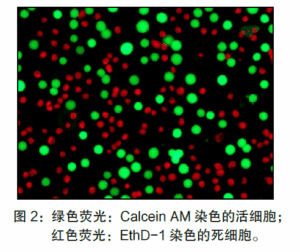

This product is easy to operate, only need to be stained for 20~30 min and then can be used for fluorescence microscopy, flow cytometry analysis, laser confocal microscopy analysis, enzyme labeling or other fluorescence detection system analysis; Wide range of application, can be used for the detection of most of the eukaryotic animal cells, but is not applicable to bacteria and yeast.
2. Calecin AM has low cytotoxicity and generally does not inhibit cell function.
3. EthD-1 has better nucleic acid binding properties and higher luminescence intensity than PI (propidium iodide).
4. It can be used for the detection of a variety of instruments, such as flow cytometry, fluorescence microscopy, laser confocal microscopy and enzyme labeling.
| individual parts making up a compound | AG51007 ( 50 rxns*1 ) | AG51008 ( 150 rxns*1 ) |
| Calcein AM (4 mM) | 12.5 μl | 37.5 μl |
| EthD-1 (2 mM) | 50 μl | 150 μl |
*1: The number of reactions in this kit is calculated as one reaction of 500 μl of working solution in one well of a 12-well plate for fluorescence microscopy. The number of reactions for different detection methods is calculated in the following table:


*2: The recommended reagent dosages in the table may be adjusted according to actual conditions.
Transportation temperature: -20℃ ice bag transportation

-scaled-1-300x300.jpg)
